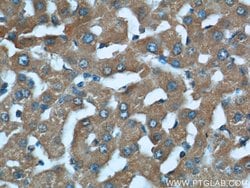
STAT3 Mouse anti-Human, Mouse, Rat, Clone: 3G2D12, Proteintech 20 &mu;L;
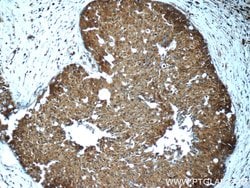
STAT3 Mouse anti-Human, Mouse, Rat, Clone: 3G2D12, Proteintech 20 &mu;L;

missing translation for 'onlineSavingsMsg'
Learn More
Learn More
STAT3 Mouse anti-Human, Mouse, Rat, Clone: 3G2D12, Proteintech
Mouse Monoclonal Antibody
Brand: Proteintech 60199-1-IG-20UL
This item is not returnable.
View return policy
Description
This antibody is a mouse monoclonal antibody raised against residues near the N terminus of human STAT3. STAT3 exists three isoforms and the molecular weight of each isoform respectively is 83 kDa, 87 kDa and 88 kDa.
STAT3 belongs to the family of STAT (signal transducers and activators of transcription) proteins which are phosphorylated by receptor associated kinases, translocate to the nucleus, and act as transcription factors in response to cytokines and growth factors. Coactivators such as CREB-binding protein are required for the transcriptional activation by STAT3. STAT3 can also be activated by Interferon-alpha, Interferon-gamma, EGF, PDGF and IL6. Phosphorylation on tyrosine 705 by JAK1 and JAK2 is essential for STAT3 dimer formation, nuclear translocation, and DNA binding activity. In humans, the STAT3 gene is located on the q arm of chromosome 17. STAT3 has been shown to be activated by IFN-alpha but not IFN-beta. The transcription factors associated with STAT3 are c-Jun and cyclic AMP-responsive enhancer binding protein (CREB). STAT3 mediates the expression of a variety of genes in response to cell stimuli, and thus plays a key role in many cellular processes such as cell growth and apoptosis. The small GTPase Rac1 has been shown to bind and regulate the activity of STAT3 while the PIAS3 protein is a specific inhibitor of STAT3. Three alternatively spliced transcript variants encoding distinct isoforms of STAT3 have been described. Deletion of the STAT3 gene in knock-out mice was lethal at the early embryonic stage.Specifications
| STAT3 | |
| Monoclonal | |
| 1.09 mg/mL | |
| PBS with 50% glycerol and 0.02% sodium azide; pH 7.3 | |
| P40763, P42227, P52631 | |
| STAT3 | |
| STAT3 Fusion Protein Ag0360 | |
| 20 μL | |
| Primary | |
| Mouse, Rat, Human | |
| Antibody | |
| IgG2a |
| Immunohistochemistry (Paraffin), Immunofluorescence, Immunoprecipitation, Immunocytochemistry, Western Blot | |
| 3G2D12 | |
| Unconjugated | |
| STAT3 | |
| Acute phase response factor, APRF, HIES, STAT3 | |
| Mouse | |
| Protein A | |
| RUO | |
| 20848, 25125, 6774 | |
| -20°C | |
| Liquid |
Correzione del contenuto del prodotto
Fornite il vostro feedback sul contenuto del prodotto compilando il modulo sottostante.
Titolo del prodotto
Individuate un'opportunità di miglioramento?Condividi una correzione di contenuto